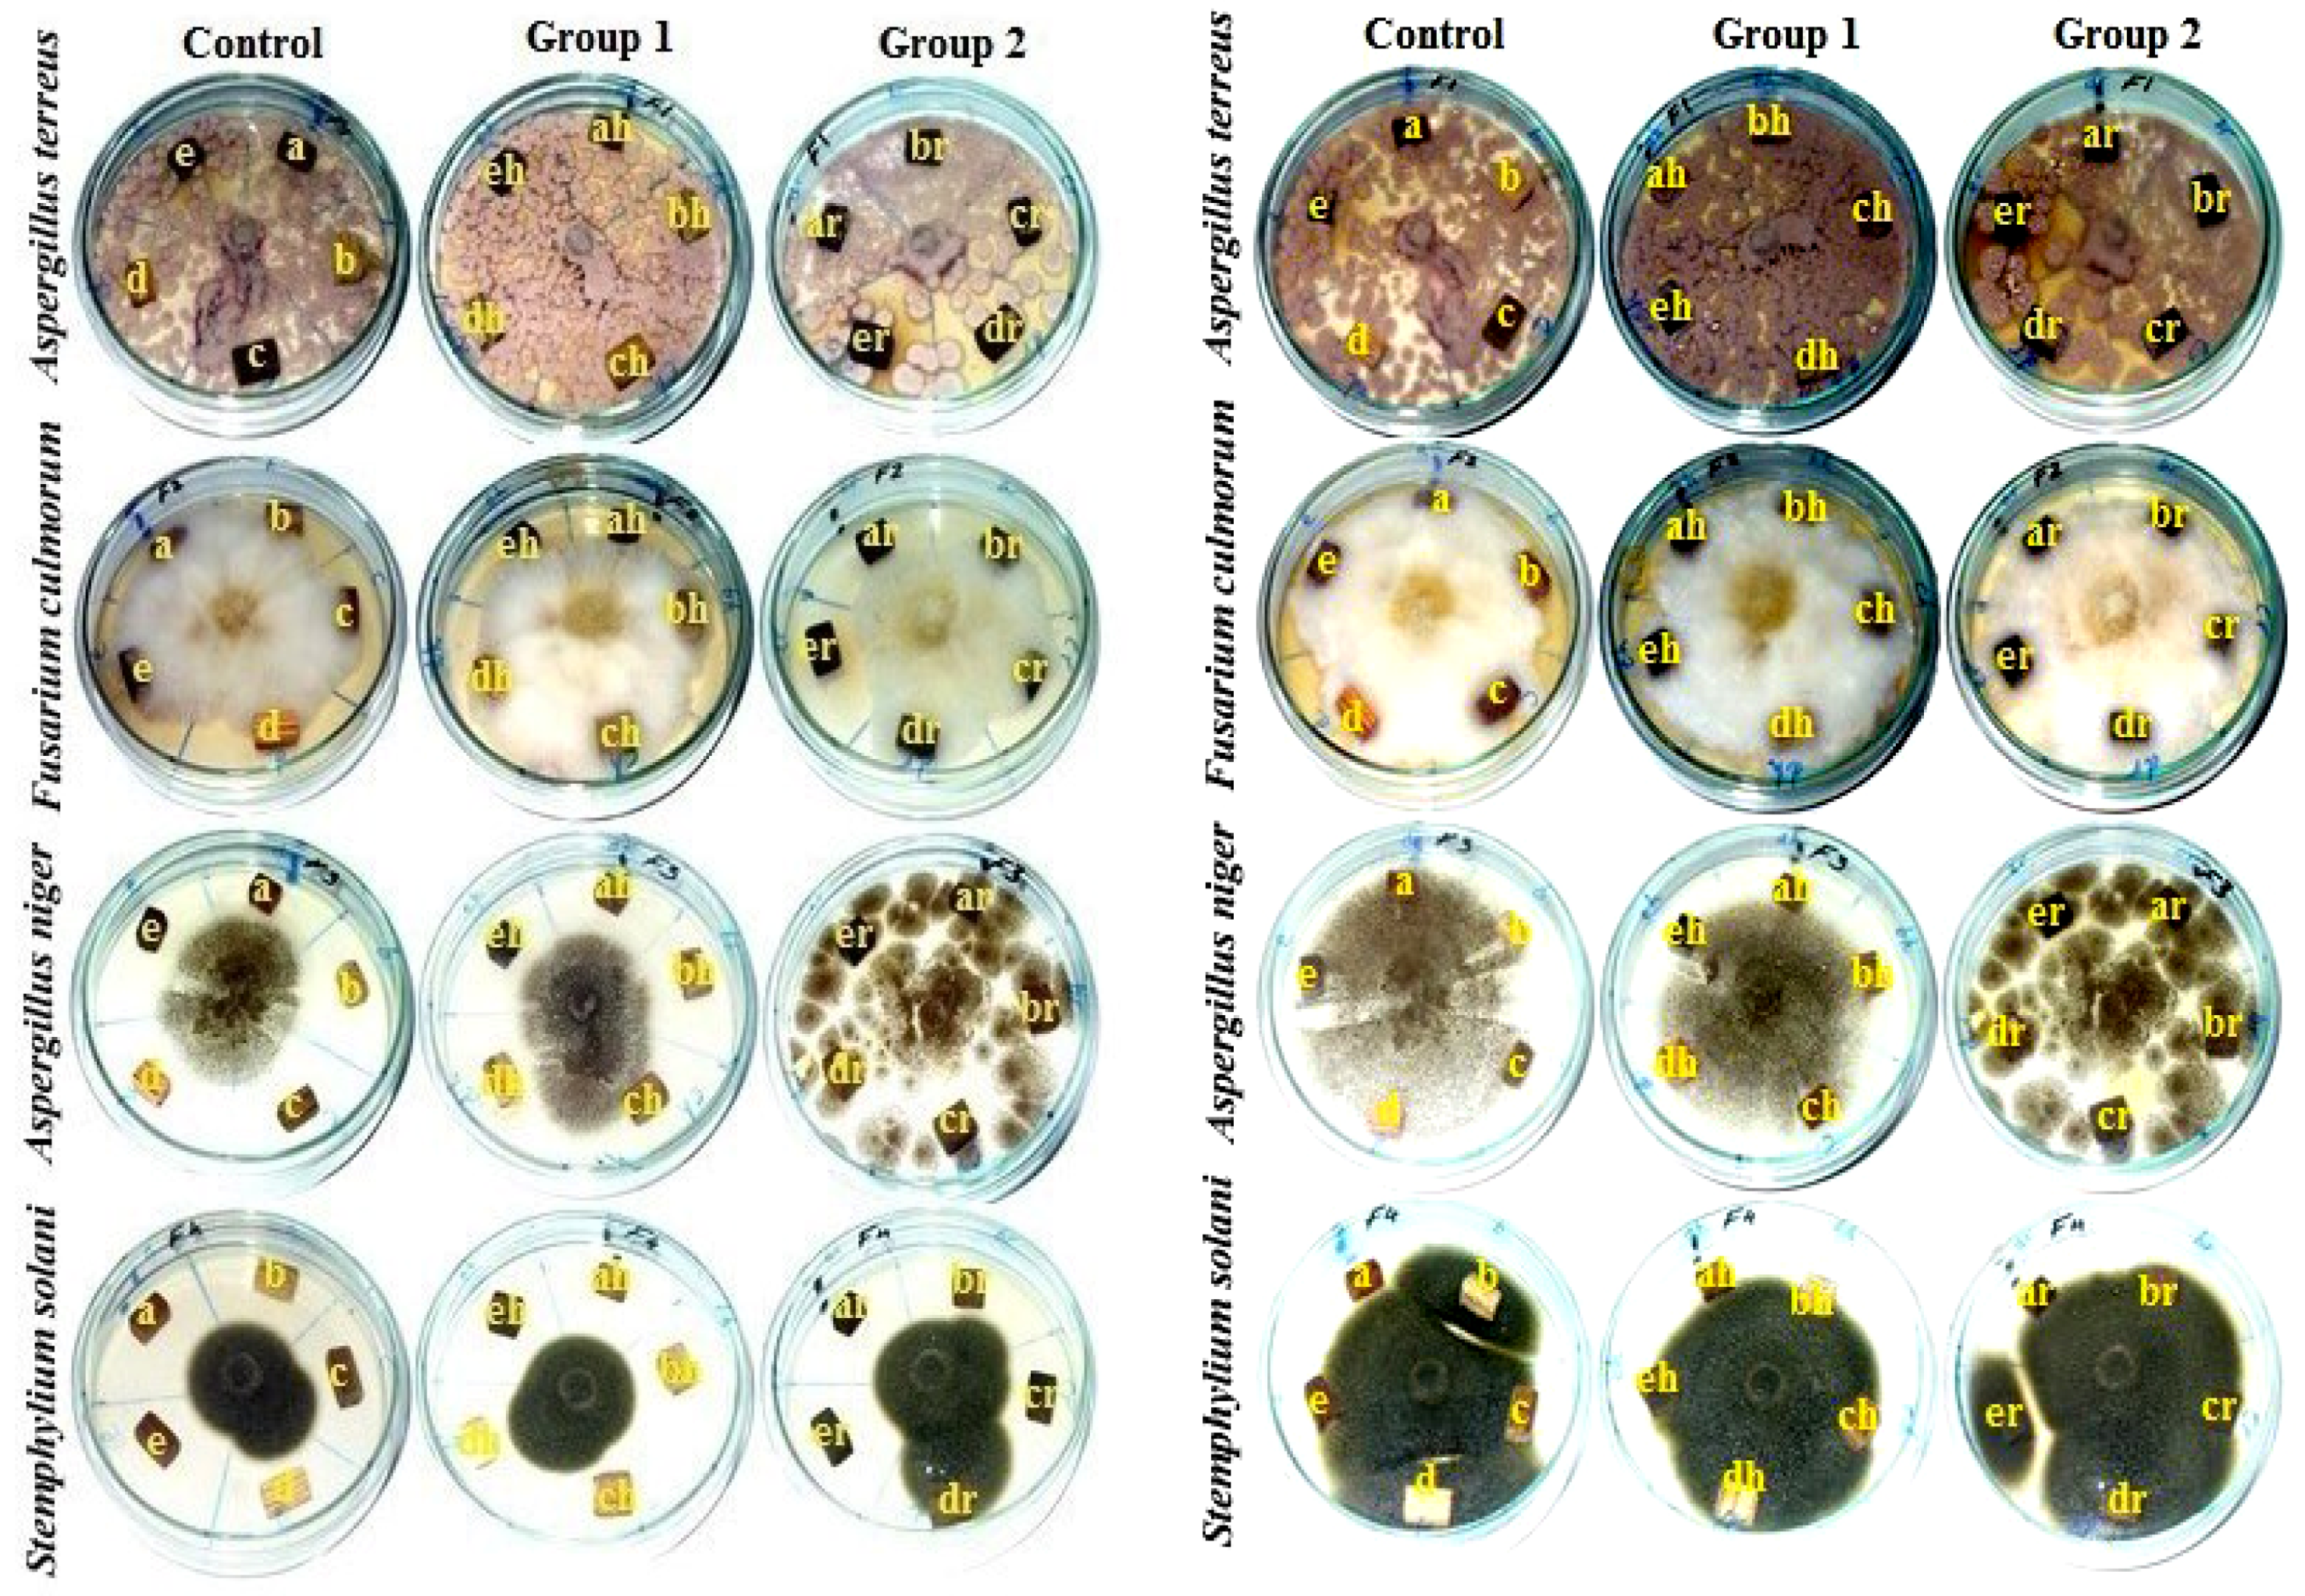

The Effects of Iron Rust on the Ageing of Woods and Their Derived Pulp Paper
Abstract
1. Introduction
2. Materials and Methods
2.1. Preparation of Raw Materials
2.2. Ageing Processes
2.3. Mechanical, Physical, Chemical and Biological Properties
2.3.1. Mechanical and Physical Properties
2.3.2. Chemical Composition of Wood Species
2.3.3. FTIR Spectroscopic Analysis of Accelerated Ageing of Wood Samples
2.3.4. Biological Activity of Accelerated Ageing of Five Wood Species In Vitro
2.4. Pulp Production
2.4.1. Kraft Pulping
2.4.2. Sheet Formation and Paper Testing
2.5. Statistical Analyses
3. Results
3.1. Properties of Age-Accelerated Wood
3.1.1. Mechanical and Physical Properties of Age-Accelerated Woods
3.1.2. Chemical Composition of the Raw Materials
3.1.3. FTIR Analyses of Accelerated Ageing of Wood Samples
3.1.4. Visual Observation of Inoculated Wood Samples after 7–14 Days
3.2. Pulp Properties
3.2.1. Yield, Kappa Number and Alkali Residue of Pulps
3.2.2. Mechanical and Optical Properties of Handsheets
4. Conclusions
Author Contributions
Funding
Institutional Review Board Statement
Informed Consent Statement
Data Availability Statement
Conflicts of Interest
References
- Hamed, S.A.-K.M.; Salem, M.Z.M.; Ali, H.M.; Ahmed, K.M.E.-S. Investigating the impact of weathering and indoor aging on wood acidity using spectroscopic analyses. BioResources 2020, 15, 6506–6525. [Google Scholar] [CrossRef]
- Kocaefe, D.; Huang, X.; Kocaefe, Y.; Boluk, Y. Quantitative characterization of chemical degradation of heat-treated wood surfaces during artificial weathering using XPS. Surf. Interface Anal. 2013, 45, 639–649. [Google Scholar] [CrossRef]
- Salim, E.; Abdel-Hamied, M.; Salim, S.; Gamal, S.; Mohamed, S.; Galal, F.E.-Z.; Tarek, F.; Hassan, R.R.A.; Ali, H.M.; Salem, M.Z.M. Reduction of borax/agar-based gel residues used to neutralize acidity of a historical manuscript with use of different paper barriers: Artificial ageing results. BioResources 2020, 15, 6576–6599. [Google Scholar] [CrossRef]
- Temiz, A.; Terziev, N.; Eikenes, M.; Hafren, J. Effect of accelerated weathering on surface chemistry of modified wood. Appl. Surf. Sci. 2007, 253, 5355–5362. [Google Scholar] [CrossRef]
- Temiz, A.; Yildiz, U.C.; Aydin, I.; Eikenes, M.; Alfredsen, G.; Çolakoglu, G. Surface roughness and color characteristics of wood treated with preservatives after accelerated weathering test. Appl. Surf. Sci. 2005, 250, 35–42. [Google Scholar] [CrossRef]
- Tshabalala, M.A.; Gangstad, J.E. Accelerated weathering of wood surfaces coated with multifunctional alkoxysilanes by sol-gel deposition. J. Coat. Technol. 2003, 75, 37–43. [Google Scholar] [CrossRef]
- Feist, W.C. Outdoor Wood Weathering and Protection. In Archaeological Wood, Properties, Chemistry, and Preservation; American Chemical Society: Washington, DC, USA, 1989; pp. 263–298. [Google Scholar] [CrossRef]
- Williams, R.S. Weathering of wood. Handb. Wood Chem. Wood Compos. 2005, 7, 139–185. [Google Scholar]
- Schmidt, P.; Porraz, G.; Slodczyk, A.; Bellot-Gurlet, L.; Archer, W.; Miller, C.E. Heat treatment in the South African Middle Stone Age: Temperature induced transformations of silcrete and their technological implications. J. Archaeol. Sci. 2013, 40, 3519–3531. [Google Scholar] [CrossRef]
- Popescu, M.C.; Froidevaux, J.; Navi, P.; Popescu, C.M. Structural modifications of Tilia cordata wood during heat treatment investigated by FT-IR and 2D IR correlation spectroscopy. J. Mol. Struct. 2013, 1033, 176–186. [Google Scholar] [CrossRef]
- Cakıcıer, N.; Korkut, S.; Korkut, D.; Kurtoğlu, A.; Sönmez, A. Effects of QUV accelerated aging on surface hardness, surface roughness, glossiness, and color difference for some wood species. Int. J. Phys. Sci. 2011, 6, 1929–1939. [Google Scholar] [CrossRef]
- Miklečić, J.; Jirouš-Rajković, V. Accelerated Weathering of Coated and Uncoated Beech Wood Modified with Citric Acid. Drv. Ind. 2011, 277–282. [Google Scholar] [CrossRef]
- Matsuo, M.; Yokoyama, M.; Umemura, K.; Sugiyama, J.; Kawai, S.; Gril, J.; Kubodera, S.; Mitsutani, T.; Ozaki, H.; Sakamoto, M.; et al. Aging of wood: Analysis of color changes during natural aging and heat treatment. Holzforschung 2011, 65, 361–368. [Google Scholar] [CrossRef]
- Akyildiz, M.H.; Saim, A. Effect of Heat Treatment on Equilibrium Moisture Content (EMC) of Some Wood Species in Turkey. Res. J. Agric. Biol. Sci. 2008, 4, 660–665. [Google Scholar]
- Baker, A. Degradation of Wood by Products of Metal Corrosion; US Department of Agriculture, Forest Service, Forest Products Laboratory: Washington, DC, USA, 1974; Volume 229.
- Zelinka, S.L.; Stone, D.S. Corrosion of metals in wood: Comparing the results of a rapid test method with long-term exposure tests across six wood treatments. Corros. Sci. 2011, 53, 1708–1714. [Google Scholar] [CrossRef]
- Zelinka, S.; Rammer, D. Review of Test Methods Used to Determine the Corrosion Rate of Metals in Contact with Treated Wood; General Technical Report; FPL-GTR-156; US Department of Agriculture, Forest Service, Forest Products Laboratory: Washington, DC, USA, 2005.
- Zelinka, S.L. Corrosion of metals in wood products. In Corrosion of Metals in Wood Products, Developments in Corrosion Protection; Aliofkhazraei, M., Ed.; InTech: London, UK, 2014; pp. 567–592. ISBN 978-953-51-1223-5. [Google Scholar] [CrossRef]
- Zelinka, S.L.; Glass, S.V.; Derome, D. The effect of moisture content on the corrosion of fasteners embedded in wood subjected to alkaline copper quaternary treatment. Corros. Sci. 2014, 83, 67–74. [Google Scholar] [CrossRef]
- Zelinka, S.L.; Stone, D.S. The effect of tannins and pH on the corrosion of steel in wood extracts. Mater. Corros. 2011, 62, 739–744. [Google Scholar] [CrossRef]
- Zelinka, S.L. Corrosion of Fasteners in Wood Treated with Newer Wood Preservatives; General Technical Report, FPL-GTR-220; USDA Forest Service, Forest Products Laboratory: Washington, DC, USA, 2013; 68p. [CrossRef][Green Version]
- Symeonidis, A.; Marangos, M. Iron and microbial growth. In Insight and Control of Infectious Disease in Global Scenario; InTech: London, UK, 2012; pp. 289–330. [Google Scholar]
- Kosman, D.J. Molecular mechanisms of iron uptake in fungi. Mol. Microbiol. 2003, 47, 1185–1197. [Google Scholar] [CrossRef] [PubMed]
- Hirayama, T. Fluorescent probes for the detection of catalytic Fe(II) ion. Free Radic. Biol. Med. 2019, 133, 38–45. [Google Scholar] [CrossRef]
- Nyilasi, I.; Papp, T.; Takó, M.; Nagy, E.; Vágvölgyi, C. Iron Gathering of Opportunistic Pathogenic Fungi. A Mini Review. Acta Microbiol. Immunol. Hung. 2005, 52, 185–197. [Google Scholar] [CrossRef]
- Xu, G.; Goodell, B. Mechanisms of wood degradation by brown-rot fungi: Chelator-mediated cellulose degradation and binding of iron by cellulose. J. Biotechnol. 2001, 87, 43–57. [Google Scholar] [CrossRef]
- Potrykus, J.; Stead, D.; Maccallum, D.M.; Urgast, D.S.; Raab, A.; Van Rooijen, N.; Feldmann, J.; Brown, A.J.P. Fungal Iron Availability during Deep Seated Candidiasis Is Defined by a Complex Interplay Involving Systemic and Local Events. PLoS Pathog. 2013, 9, e1003676. [Google Scholar] [CrossRef]
- Howard, D.H. Acquisition, Transport, and Storage of Iron by Pathogenic Fungi. Clin. Microbiol. Rev. 1999, 12, 394–404. [Google Scholar] [CrossRef]
- Salem, M.Z.M.; Alotaibi, S.; Abo Elgat, W.A.A.; Taha, A.; Fares, Y.; El-Shehawi, A.; Ghareeb, R. Antifungal Activities of Wood and Non-Wood Kraft Handsheets Treated with Melia azedarach Extract Using SEM and HPLC Analyses. Polymers 2021, 13, 2012. [Google Scholar] [CrossRef]
- Salem, M.Z.M.; Ali, H.M.; Akrami, M. Moringa oleifera seeds-removed ripened pods as alternative for papersheet production: Antimicrobial activity and their phytoconstituents profile using HPLC. Sci. Rep. 2021, 11, 19027. [Google Scholar] [CrossRef] [PubMed]
- Taha, A.S.; Abo Elgat, W.A.A.; Fares, Y.G.D.; Dessoky, E.S.; Behiry, S.I.; Salem, M.Z.M. Using plant extractives as eco-friendly pulp additives: Mechanical and antifungal properties of paper sheets made from linen fibers. BioResources 2021, 16, 2589–2606. [Google Scholar] [CrossRef]
- Strlič, M.; Grossi, C.M.; Dillon, C.; Bell, N.; Fouseki, K.; Brimblecombe, P.; Menart, E.; Ntanos, K.; Lindsay, W.; Thickett, D.; et al. Damage function for historic paper. Part III: Isochrones and demography of collections. Heritage Sci. 2015, 3, 40. [Google Scholar] [CrossRef]
- Hassan, R.R.A.; Mahmoud, S.M.A.; Karam, Y.A.; Salah, S.M.; Ebrahim, S.Y.; Abdelwahab, M.A.; Ahmed, A.-H.M.H.; Ali, H.M.; Böhm, M.; Salem, M.Z.M. Application of Frankincense and Rice Starch as Eco-Friendly Substances for the Resizing of Paper as a Conservation Practice. BioResources 2021, 16, 7180–7204. [Google Scholar] [CrossRef]
- Rebrikova, N.L.; Manturovskaya, N.V. Foxing—A New Approach to an Old Problem. Restaurator 2000, 21, 85–100. [Google Scholar] [CrossRef]
- Ghorbani, M.; Samanian, K.; Afsharpuor, M. Effect of physical properties of bacterial cellulose nanofibers bio-composite as a coating on the paper works. Int. J. Conserv. Sci. 2018, 9, 71–80. [Google Scholar]
- Baglioni, P.; Giorgi, R. Soft and hard nanomaterials for restoration and conservation of cultural heritage. Soft Matter 2006, 2, 293–303. [Google Scholar] [CrossRef] [PubMed]
- Budakçi, M.; Korkut, D.S. The color changes on varnish layers after accelerated aging through the hot and cold-check test. Afr. J. Biotechnol. 2010, 9, 3595–3602. [Google Scholar]
- Froidevaux, J.; Volkmer, T.; Gril, J.; Fioravanti, M.; Navi, P. Comparison between accelerated thermo-hydro aged wood and naturally aged wood. In Proceedings of the 1st Workshop of COST Action FP0904’Mechano-Chemical Transformations of Wood during Thermo-Hydro-Mechanical Processing, Bienne, Switzerland, 16 February 2011. [Google Scholar]
- Altinok, M.; Ozalp, M.; Korkut, S. The effects of heat treatment on some mechanical properties of laminated beech (Fagus orientalis L.) wood. Wood Res. 2010, 55, 131–142. [Google Scholar]
- Matsuo, M.; Yokoyama, M.; Umemura, K.; Sugiyama, J.; Kawai, S.; Gril, J.; Yano, K.I.; Kubodera, S.; Mitsutani, T.; Ozaki, H. Evaluation of the aging wood from historical buildings as compared with the accelerated aging wood and cellulose, Analysis of color properties. In Proceedings of the International Conference on Wooden Cultural Heritage, Evaluation of Deterioration and Management of Change, Hamburg, Germany, 7–10 October 2009; p. 6. [Google Scholar]
- Yokoyama, M.; Gril, J.; Matsuo, M.; Yano, H.; Sugiyama, J.; Clair, B.; Kubodera, S.; Mistutani, T.; Sakamoto, M.; Ozaki, H. Mechanical characteristics of aged Hinoki (Chamaecyparis obtusa Endl.) wood from Japanese historical buildings. In Proceedings of the International Conference on Wooden Cultural Heritage, Evaluation of Deterioration and Management of Change, Hamburg, Germany, 7–10 October 2009; p. 8. [Google Scholar]
- Colmars, J.; Gril, J.; Yano, H.; Nakano, T. Creep Properties of Heat Treated Wood in Radial Direction. In Proceedings of the Joint meeting of COST Action IE0601 WoodCultHer Wood Science for Conservation of Cultural Heritage, and the European Society of Wood Mechanics, Braga, Portugal, 5–7 November 2008; pp. 24–29. [Google Scholar]
- American Wood Preservers’ Association. Standard Method of Determining Corrosion of Metal in Contact with Treated Wood; AWPA E12-94; American Wood Preservers’ Association: Selma, AL, USA, 2014. [Google Scholar]
- American Society for Testing and Materials. Standard Practice for Operating Salt Spray (Fog) Apparatus; ASTM, B-117-03; American Society for Testing and Materials: West Conshohocken, PA, USA, 2003. [Google Scholar]
- McNatt, J.D.; Link, C.L. Analysis of ASTM D 1037 accelerated-aging test. For. Prod. J. 1989, 39, 51–57. [Google Scholar]
- American Society for Testing and Materials. Standard Test Methods for Evaluating Properties of Wood-Based Fiber and Particle Panel Materials; ASTM, Designation: D 1037-06A; American Society for Testing and Materials: West Conshohocken, PA, USA, 2006. [Google Scholar]
- Nasser, R.A.; Salem, M.Z.M.; Al-Mefarrej, H.A.; Aref, I.M. Measurement of Some Strength Properties and the Chemical Compositions of Seven Hardwood Species Grown in Northwest Egypt. J. Test. Eval. 2016, 44, 20140532. [Google Scholar] [CrossRef]
- British Standard Methods of Testing Small Clear Specimens of Timber. London, UK. Available online: http://211.167.243.154:1012/file/gwbz/BSþ373-1957.pdf (accessed on 18 September 2021).
- Bektaş, İ.; Ramazan, K. Principal mechanical properties of cypress wood (Cupressus Sempervirens L.) naturally grown in (Kahramanmaraş) Eastern Mediterranean of Turkey. Gazi Univ. J. Sci. 2010, 23, 357–362. [Google Scholar]
- Korkut, S.; Guller, B. Physical and mechanical properties of European Hophornbeam (Ostrya carpinifolia Scop.) wood. Bioresour. Technol. 2008, 99, 4780–4785. [Google Scholar] [CrossRef] [PubMed]
- Zeidler, A.; Salem, M.Z.M.; Borůvka, V. Mechanical Properties of Grand Fir Wood Grown in the Czech Republic in Vertical and Horizontal Positions. BioResources 2015, 10, 793–808. [Google Scholar] [CrossRef]
- American Society for Testing and Materials (ASTM). D143-14. Standard Test Methods for Small Clear Specimens of Timber; ASTM International: West Conshohocken, PA, USA, 2014. [Google Scholar]
- El-Osta, M. Some strength properties of Juniper southwest Saudi Arabia. J. Coll. Agric. King Saud. Univ. 1985, 7, 103–112. [Google Scholar]
- American Society for Testing and Materials (ASTM). D2395-84: Standard Test Method for Specific Gravity of Wood and Wood-Base Materials—Method A; ASTM International: West Conshohocken, PA, USA, 1989. [Google Scholar]
- Salem, M.Z.M.; Elgat, W.A.A.A.; Taha, A.S.; Fares, Y.G.D.; Ali, H.M. Impact of Three Natural Oily Extracts as Pulp Additives on the Mechanical, Optical, and Antifungal Properties of Paper Sheets Made from Eucalyptus camaldulensis and Meryta sinclairii Wood Branches. Materials 2020, 13, 1292. [Google Scholar] [CrossRef] [PubMed]
- Salem, M.Z.M.; Zidan, Y.E.; El Hadidi, N.M.; Mansour, M.M.; Abo Elgat, W.A.A. Evaluation of usage three natural extracts applied to three commercial wood species against five common molds. Int. Biodeterior. Biodegrad. 2016, 110, 206–226. [Google Scholar] [CrossRef]
- Taha, A.S.; Abo Elgat, W.A.A.; Salem, M.Z.M.; Ali, H.M.; Fares, Y.G.; Elshikh, M.S. Impact of some plant source additives on enhancing the properties and antifungal activities of pulp made from Linen fibers. BioResources 2019, 14, 6025–6046. [Google Scholar]
- Miklečić, J.; Španić, N.; Jirouš-Rajković, V. Wood color changes by ammonia fuming. BioResources 2012, 7, 3767–3778. [Google Scholar]
- Essa, A.M.; Khallaf, M.K. Biological nanosilver particles for the protection of archaeological stones against microbial colonization. Int. Biodeterior. Biodegrad. 2014, 94, 31–37. [Google Scholar] [CrossRef]
- Mansour, M.M.A.; Abdel-Megeed, A.; Nasser, R.A.; Salem, M.Z.M. Comparative Evaluation of Some Woody Tree Methanolic Extracts and Paraloid B-72 against Phytopathogenic Mold Fungi Alternaria tenuissima and Fusarium culmorum. BioResources 2015, 10, 2570–2584. [Google Scholar] [CrossRef]
- Mansour, M.M.A.; Nasser, R.A.; Salem, M.Z.M.; Ali, H.M.; Hatamleh, A. Study of Mold Invasion on the Surface of Wood/Polypropylene Composites Produced from Aqueous Pretreated Wood Particles, Part 2: Juniperus procera Wood-Branch. BioResources 2017, 12, 4187–4201. [Google Scholar] [CrossRef]
- Mansour, M.M.; Salem, M.Z.M. Evaluation of wood treated with some natural extracts and Paraloid B-72 against the fungus Trichoderma harzianum: Wood elemental composition, in-vitro and application evidence. Int. Biodeterior. Biodegrad. 2015, 100, 62–69. [Google Scholar] [CrossRef]
- Nasser, R.; Mansour, M.M.A.; Salem, M.Z.M.; Ali, H.M.; Aref, I.M. Mold Invasion on the Surface of Wood/Polypropylene Composites Produced from Aqueous Pretreated Wood Particles, Part 1: Date Palm Midrib. BioResources 2017, 12. [Google Scholar] [CrossRef]
- The Statistical Analysis System (SAS). Users Guide: Statistics (Release 8.02); SAS Institute Inc.: Cary, NC, USA, 2001. [Google Scholar]
- Naumann, A.; Sudhakar, P.; Andrea, P. Fourier Transform Infrared Microscopy in Wood Analysis. In Wood Production, Wood Technology, and Biotechnological Impacts; Kües, U., Ed.; Universitätsverlag Göttingen, The Georg August University of Göttingen: Göttingen, Germany, 2007; p. 179. ISBN 978-3-940344-11-3. [Google Scholar]
- Popescu, C.-M.; Popescu, M.-C.; Singurel, G.; Vasile, C.; Argyropoulos, D.; Willför, S. Spectral Characterization of Eucalyptus Wood. Appl. Spectrosc. 2007, 61, 1168–1177. [Google Scholar] [CrossRef] [PubMed]
- Báder, M.; Németh, R.; Sandak, J.; Sandak, A. FTIR analysis of chemical changes in wood induced by steaming and longitudinal compression. Cellulose 2020, 27, 6811–6829. [Google Scholar] [CrossRef]
- Nuopponen, M. FT-IR and UV Raman Spectroscopic Studies on Thermal Modification of Scots Pine Wood and Its Extractable Compounds; Series A, 23; Laboratory of Forest Products Chemistry, Helsinki University of Technology: Espoo, Finland, 2005. [Google Scholar]
- Zhao, J.; Xiuwen, W.; Hu, J.; Liu, Q.; Shen, D.; Xiao, R. Thermal degradation of softwood lignin and hardwood lignin by TG-FTIR and Py-GC/MS. Polym. Degrad. Stab. 2014, 108, 133–138. [Google Scholar] [CrossRef]
- Yassin, Z.; El Hadidi, N.N.; Mohamed, M.F. Examination and Analyses of a Wooden Face a The Museum Storage at The Faculty of Archaeology, Cairo University. Mediterr. Archaeol. Archaeom. 2016, 16, 1–11. [Google Scholar] [CrossRef]
- Shi, J.; Xing, D.; Lia, J. FTIR Studies of the Changes in Wood Chemistry from Wood Forming Tissue under Inclined Treatment. Energy Procedia 2012, 16, 758–762. [Google Scholar] [CrossRef]
- Bodirlau, R.; Teaca, C. Fourier transform infrared spectroscopy and thermal analysis of lignocellulose fillers treated with organic anhydrides. Rom. J. Phys. 2009, 54, 93–104. [Google Scholar]
- Kavkler, K.; Demsar, A. Application of FTIR and Raman spectroscopy to qualitative analysis of structural changes in cellulosic fibres. Tekstilec 2012, 55, 19–31. [Google Scholar]
- Müller, G.; Schöpper, C.; Vos, H.; Kharazipour, A.; Polle, A. FTIR-ATR spectroscopic analyses of changes in wood properties during particle-and fibreboard production of hard-and softwood trees. BioResources 2009, 4, 49–71. [Google Scholar]
- Tjeerdsma, B.F.; Militz, H. Chemical changes in hydrothermal treated wood: FTIR analysis of combined hydrothermal and dry heat-treated wood. Holz Roh Werkst. 2005, 63, 102–111. [Google Scholar] [CrossRef]
- Chen, H.; Ferrari, C.; Angiuli, M.; Yao, J.; Raspi, C.; Bramanti, E. Qualitative and quantitative analysis of wood samples by Fourier transform infrared spectroscopy and multivariate analysis. Carbohydr. Polym. 2010, 82, 772–778. [Google Scholar] [CrossRef]
- Bonifazi, G.; Calienno, L.; Capobianco, G.; Monaco, A.L.; Pelosi, C.; Picchio, R.; Serranti, S. Modeling color and chemical changes on normal and red heart beech wood by reflectance spectrophotometry, Fourier Transform Infrared spectroscopy and hyperspectral imaging. Polym. Degrad. Stab. 2015, 113, 10–21. [Google Scholar] [CrossRef]
- Traoré, M.; Kaal, J.; Cortizas, A.M. Application of FTIR spectroscopy to the characterization of archeological wood. Spectrochim. Acta Part A Mol. Biomol. Spectrosc. 2016, 153, 63–70. [Google Scholar] [CrossRef]
- Li, M.-Y.; Cheng, S.-C.; Li, D.; Wang, S.; Huang, A.-M.; Sun, S.-Q. Structural characterization of steam-heat treated Tectona grandis wood analyzed by FT-IR and 2D-IR correlation spectroscopy. Chin. Chem. Lett. 2015, 26, 221–225. [Google Scholar] [CrossRef]
- Parida, C.; Dash, S.K.; Pradhan, C. FTIR and Raman Studies of Cellulose Fibers of Luffa cylindrica. Open J. Compos. Mater. 2014, 5, 5–10. [Google Scholar] [CrossRef]
- Poletto, M.; Zattera, A.J.; Santana, R.M.C. Structural differences between wood species: Evidence from chemical composition, FTIR spectroscopy, and thermogravimetric analysis. J. Appl. Polym. Sci. 2012, 126, E337–E344. [Google Scholar] [CrossRef]
- Traoré, M.; Kaal, J.; Cortizas, A.M. Differentiation between pine woods according to species and growing location using FTIR-ATR. Wood Sci. Technol. 2018, 52, 487–504. [Google Scholar] [CrossRef]
- Gelbrich, J.; Mai, C.; Militz, H. Chemical changes in wood degraded by bacteria. Int. Biodeterior. Biodegrad. 2008, 61, 24–32. [Google Scholar] [CrossRef]
- Sundqvist, B. Colour Changes and Acid Formation in Wood during Heating. Doctoral Thesis, Luleå Tekniska Universitet, Luleå, Sweden, 2004. [Google Scholar]
- Bhuiyan, T.R.; Hirai, N.; Sobue, N. Changes of crystallinity in wood cellulose by heat treatment under dried and moist conditions. J. Wood Sci. 2000, 46, 431–436. [Google Scholar] [CrossRef]
- Hakkou, M.; Pétrissans, M.; Zoulalian, A.; Gérardin, P. Investigation of wood wettability changes during heat treatment on the basis of chemical analysis. Polym. Degrad. Stab. 2005, 89, 1–5. [Google Scholar] [CrossRef]
- Awoyemi, L.; Westermark, U. Effects of borate impregnation on the response of wood strength to heat treatment. Wood Sci. Technol. 2005, 39, 484–491. [Google Scholar] [CrossRef]
- Beech, I.B.; Gaylarde, C. Recent advances in the study of biocorrosion: An overview. Rev. Microbiol. 1999, 30, 117–190. [Google Scholar] [CrossRef]
- Ecaza, M.; Kronstad, J.W. Shared and distinct mechanisms of iron acquisition by bacterial and fungal pathogens of humans. Front. Cell. Infect. Microbiol. 2013, 3, 80. [Google Scholar] [CrossRef]
- Gerwien, F.; Safyan, A.; Wisgott, S.; Brunke, S.; Kasper, L.; Hube, B. The Fungal Pathogen Candida glabrata Does Not Depend on Surface Ferric Reductases for Iron Acquisition. Front. Microbiol. 2017, 8, 1055. [Google Scholar] [CrossRef] [PubMed]
- Stanford, F.; Voigt, K. Iron Assimilation during Emerging Infections Caused by Opportunistic Fungi with emphasis on Mucorales and the Development of Antifungal Resistance. Genes 2020, 11, 1296. [Google Scholar] [CrossRef]
- Lugauskas, A.; Demčenko, I.; Selskienė, A.; Pakštas, V.; Jaskelevičius, B.; Narkevičius, A.; Bučinskienė, D. Resistance of Chromated Zinc Coatings to the Impact of Microscopic Fungi. Mater. Sci. 2011, 17, 20–26. [Google Scholar] [CrossRef]
- Charng, T.; Lansing, F. Review of corrosion causes and corrosion control in a technical facility. TDA Prog. Rep. 1982, 42, 145–156. [Google Scholar]
- Gu, T. New Understandings of Biocorrosion Mechanisms and their Classifications. J. Microb. Biochem. Technol. 2012, 4, 4. [Google Scholar] [CrossRef]

| Step | Exposure | Temperature (°C) | Time (h) |
|---|---|---|---|
| 1 | Water soak | 49 | 2 |
| 2 | Dry-air heat | 99 | 4 |
| 3 | Water soak | 49 | 2 |
| 4 | Dry-air heat | 99 | 16 |
| Wood Species | Treatment | MOR (MPa) | MTS (MPa) | Cmax (MPa) | Density (g/cm3) | MC (%) |
|---|---|---|---|---|---|---|
| Erythrina humeana | Control | 28.91 ± 2 H | 20.74 ± 2 I | 11.94 ± 1.4 G | 0.227 ± 0.04 | 12.51 ± 0.75 |
| Heated | 28.03 ± 3 H | 16.29 ± 4 I | 12.12 ± 1.9 G | 0.227 ± 0.02 | 10.31 ± 0.56 | |
| Rusted | 23.53 ± 6 H | 16.38 ± 4 I | 13.54 ± 1.5 G | 0.214 ± 0.01 | 10.11 ± 0.13 | |
| Pinus rigida | Control | 120.46 ± 8 C–E | 130.52 ± 4 A | 57.82 ± 3.0 BC | 0.595 ± 0.02 | 11.34 ± 0.28 |
| Heated | 139.65 ± 20 AB | 60.18 ± 8 GH | 52.90 ± 8.2 DE | 0.599 ± 0.04 | 10.53 ± 0.14 | |
| Rusted | 124.87 ± 11 CD | 89.89 ± 21 DE | 53.01 ± 4.9 DE | 0.594 ± 0.03 | 9.91 ± 0.33 | |
| Schinus terebinthifolius | Control | 102.70 ± 4 G | 80.22 ± 6 EF | 54.45 ± 0.6 C–E | 0.538 ± 0.02 | 11.82 ± 0.67 |
| Heated | 105.96 ± 8 F | 64.81 ± 15 G | 43.40 ± 6.3 F | 0.558 ± 0.04 | 10.33 ± 0.42 | |
| Rusted | 112.05 ± 10 E–G | 50.93 ± 5 H | 51.99 ± 5.5 E | 0.576 ± 0.02 | 11.93 ± 3.35 | |
| Tectona grandis | Control | 129.18 ± 21 BC | 109.85 ± 26 B | 65.26 ± 1.3 A | 0.588 ± 0.04 | 10.00 ± 0.46 |
| Heated | 115.79 ± 9 D–F | 102.32 ± 12 BC | 64.46 ± 3.2 A | 0.544 ± 0.02 | 8.45 ± 0.15 | |
| Rusted | 123.70 ± 7 CD | 94.24 ± 3 CD | 58.75 ± 4.0 B | 0.561 ± 0.01 | 7.34 ± 0.25 | |
| Juglans nigra | Control | 126.10 ± 25 CD | 103.17 ± 17 BC | 45.09 ± 5.4 F | 0.550 ± 0.07 | 10.07 ± 0.51 |
| Heated | 107.23 ± 12 FG | 83.59 ± 22 DE | 55.61 ± 5.4 B–D | 0.543 ± 0.03 | 8.67 ± 0.22 | |
| Rusted | 144.18 ± 15 A | 69.80 ± 10 FG | 51.60 ± 5.6 E | 0.565 ± 0.08 | 9.32 ± 0.69 | |
| LSD0.05 | 11.67 | 12.21 | 3.96 | NS | NS | |
| Wood Species | Treatment | Alcohol:benzene Extractives Content (%) | Lignin Content (%) | Holocellulose Content (%) | Ash Content (%) |
|---|---|---|---|---|---|
| Tectona grandis | Control | 8.23 ± 0.05 B | 29.33± 0.57 AB | 59.95 ± 0.005 N | 2.86 ± 0.01 C |
| Heated | 7.16 ± 0.005 E | 29.66± 0.57 A | 61.22 ± 0.005 M | 1.96 ± 0.05 G | |
| Rusted | 6.83 ± 0.05 F | 29.66 ± 0.57 A | 61.34 ± 0.005 L | 1.87 ± 0.01 H | |
| Schinus terebinthifolius | Control | 9.30 ± 0.10 A | 24.33 ± 0.57 G | 63.76 ± 0.11 I | 2.86 ± 0.05 C |
| Heated | 7.85 ± 0.005 C | 25.56 ± 0.05 F | 64.56 ± 0.05 H | 2.03± 0.01 F | |
| Rusted | 7.65 ± 0.005 D | 24.33 ± 0.57 G | 65.82± 0.01 F | 1.52 ± 0.005 I | |
| Erythrina humeana | Control | 8.16± 0.01 B | 25.66 ± 0.57 EF | 61.86± 0.02 K | 3.96 ± 0.005 A |
| Heated | 7.77 ± 0.01 CD | 26.66 ± 0.57 DE | 62.91± 0.005 J | 3.40 ± 0.1 B | |
| Rusted | 5.55 ± 0.005 H | 26.33 ± 0.57 EF | 64.50 ± 0.10 H | 2.85 ±0.005 C | |
| Pinus rigida | Control | 4.36 ± 0.208 J | 28.43 ± 0.11 BC | 64.92 ± 0.01 G | 2.37 ± 0.01 D |
| Heated | 3.33 ± 0.02 K | 27.66 ± 1.52 CD | 66.63 ± 0.208 E | 0.85 ± 0.005 K | |
| Rusted | 2.56± 0.05 L | 29.60 ± 0.20 A | 67.15 ± 0.01 D | 0.43± 0.005 M | |
| Juglans nigra | Control | 6.86 ± 0.005 F | 22 ± 1 H | 69.97 ± 0.01 C | 2.14 ± 0.01 E |
| Heated | 5.73 ± 0.05 G | 22.33 ± 0.57 H | 71.25 ± 0.01 B | 0.93 ± 0.005 J | |
| Rusted | 5.16 ± 0.11 I | 22.60 ± 0.20 H | 71.46 ± 0.03 A | 0.62 ± 0.01 L | |
| LSD 0.05 | 0.1224 | 1.09 | 0.116 | 0.057 | |
| p-value | <0.0001 | 0.0336 | <0.0001 | <0.0001 | |
| Wavenumbers (cm−1) * | Functional Group Bands | Assignment |
|---|---|---|
| 3461 | OH stretching | Cellulose, lignin and hemicellulose |
| 2821–2953 | CH2 stretching | Cellulose, lignin and hemicellulose |
| 1734 | Unconjugated C=O stretching | Hemicellulose |
| 1632–1658 | Conjugated C=O stretching + H-O-H absorption | Due to oxidation of cellulose |
| 1507 | C=C stretching of the aromatic ring | Lignin |
| 1428 | CH2 bending | Cellulose (crystallized and amorphous) |
| 1164 | O-C-O stretching | Cellulose polymerization |
| 1044 | C-O stretching | Cellulose, lignin and hemicellulose |
| 898 | O-C-O stretching | Crystallized cellulose |
| Species | Treatment | Pulp Yield (%) | Kappa Number | Residual Alkali (g/L) |
|---|---|---|---|---|
| Tectona grandis | Control | 39.46 ± 0.11 DE | 23.33 ± 0.57 GH | 28.66 ± 1.52 B |
| Heated | 34.63 ± 0.05 J | 21.66 ± 1.15 H | 25.66 ± 0.57 D | |
| Rusted | 36.66 ± 0.57 I | 18.33± 0.57 I | 19.66 ± 0.57 F | |
| Schinus terebinthifolius | Control | 39.4 ± 0.1 DE | 33.66 ± 0.57 A | 18.43 ± 0.11 H |
| Heated | 36.23 ± 0.11 I | 28.33 ± 1.15 BC | 15.46± 0.05 J | |
| Rusted | 38.83 ± 0.05 EF | 28.33± 0.57 BC | 13.50 ± 0.10 K | |
| Erythrina humeana | Control | 39.66 ± 0.57 D | 27.66 ± 1.15 CD | 32.43 ± 0.15 A |
| Heated | 37.56 ± 0.05 GH | 26 ± 1 DE | 23.46 ± 0.05 E | |
| Rusted | 38.33 ± 1.15 F | 25.66 ± 1.52 EF | 18.86 ± 0.057 F-H | |
| Pinus rigida | Control | 44.33 ± 0.57 A | 29.66 ± 0.57 B | 27.3 ± 0.1 C |
| Heated | 41.33 ± 0.57 C | 28b ± 1 C | 18.6 ± 0.2 GH | |
| Rusted | 43.56 ± 0.11 B | 26 ± 2 DE | 15.53 ± 0.02 J | |
| Juglans nigra | Control | 39.56 ± 0.15 D | 26.66c ± 0.57 DE | 27.33 ± 1.15 C |
| Heated | 37.4 ± 0.10 H | 24 ± 2 FG | 19.46 ± 0.11 FD | |
| Rusted | 38.16 ± 0.11 FG | 22.66 ± 0.57 GH | 17 ± 1 I | |
| p-value | <0.0001 | 0.0373 | <0.0001 | |
| Wood species | Treatment | Mechanical Properties | Optical Properties | Grammage (g/m2) | ||||
|---|---|---|---|---|---|---|---|---|
| Tensile Strength Nm/g | Tear Resistance mN·m2/g | Burst Strength kPa·m2/g | Fold Number | Brightness (%) | Opacity (%) | |||
| Tectona grandis | Control | 57.06 ± 0.66 E | 7.83 ± 0.58 B | 7.49 ± 0.56 B | 114.66 ± 0.57 C | 18.33 ± 0.57 I | 75.66 ± 0.57 B | 60.13 ± 0.05 |
| Heated | 44.56 ± 0.02 I | 4.47 ± 0.05 F | 3.36 ± 0.02 F | 102.33 ± 1.15 E | 15.33 ± 0.57 J | 83.66 ± 0.57 A | 60.16 ± 0.05 | |
| Rusted | 52.33 ± 0.57 F | 6.23 ± 0.01 C | 4.75 ± 0.02 E | 105.33 ± 0.57 D | 16.33 ± 0.57 J | 82.66 ± 0.57 A | 60.16 ± 0.05 | |
| Schinus terebinthifolius | Control | 59.66 ± 0.57 D | 5.6 ± 0.57 D | 4.38 ± 0.57 E | 9.66 ± 0.57 L | 29.66 ± 0.57 D | 65.33 ± 0.57 EF | 60.2 ± 0.1 |
| Heated | 50.66 ± 0.57 G | 3.25 ± 0.005 G | 3.44 ± 0.005 F | 8.33 ± 1.15 L | 25.33 ± 0.57 G | 72.66 ± 0.57 C | 60.16 ± 0.05 | |
| Rusted | 56.63 ± 0.05 E | 3.35 ± 0.01 G | 3.76 ± 0.11 F | 8.66 ± 0.57 L | 28.66 ± 0.57 DE | 76.66 ± 1.52 B | 60.16 ± 0.11 | |
| Erythrina humeana | Control | 48.66 ± 0.57 H | 4.63 ± 0.56 F | 4.75 ± 0.01 E | 46 ± 1 F | 27.33 ± 0.57 EF | 62 ± 1.73 G | 60.2 ± 0.1 |
| Heated | 40.33 ± 0.57 K | 2.17 ± 0.011 H | 2.14 ± 0.01 H | 38.66 ± 0.57 H | 23.33 ± 1.52 H | 75.33 ± 1.52 BC | 60.20 ± 0.10 | |
| Rusted | 44.66 ± 0.57 I | 2.46 ± 0.11 H | 2.6 ± 0.1 G | 42.66 ± 0.57 G | 24.33 ± 1.15 HG | 68.33 ± 0.57 D | 60.20 ± 0.10 | |
| Pinus rigida | Control | 69.66 ± 0.57 A | 8.68 ± 0.58 A | 8.19 ± 0.58 A | 195.66 ± 0.57 A | 29.66 ± 0.57 D | 67.66 ± 1.52 DE | 60.23 ± 0.11 |
| Heated | 65.66 ± 1.52 C | 6.64 ± 0.01 C | 5.34 ± 0.02 D | 186.33 ± 1.52 B | 24.66 ± 1.52 HG | 75.66 ± 1.52 B | 60.23 ± 0.05 | |
| Rusted | 68.33 ± 1.15 B | 7.56 ± 0.15 B | 5.85 ± 0.01 D | 185.66 ± 0.57 B | 27 ± 1 F | 74.66 ± 1.15 BC | 60.26 ± 0.05 | |
| Juglans nigra | Control | 45.29 ± 1.16 I | 6.54 ± 0.005 C | 5.82 ± 0.01 D | 24.66 ± 0.57 I | 38.66 ± 0.57 A | 55.3 ± 0.57 H | 60.16 ± 0.05 |
| Heated | 40.82 ± 0.005 K | 4.87 ± 0.02 EF | 3.55 ± 0.02 F | 22 ± 1.73 J | 31.33 ± 0.57 C | 63 ± 1 FG | 60.2 ± 0.1 | |
| Rusted | 42.56 ± 0.05 J | 5.23 ± 0.01 DE | 3.64 ± 0.005 F | 20.33 ± 1.52 K | 35.33 ± 0.57 B | 63 ± 5.19 FG | 60.2 | |
| p-value | <0.0001 | <0.0001 | <0.0001 | <0.0001 | 0.0028 | <0.0001 | 0.9964 | |
Publisher’s Note: MDPI stays neutral with regard to jurisdictional claims in published maps and institutional affiliations. |
© 2021 by the authors. Licensee MDPI, Basel, Switzerland. This article is an open access article distributed under the terms and conditions of the Creative Commons Attribution (CC BY) license (https://creativecommons.org/licenses/by/4.0/).
Share and Cite
Abo Elgat, W.A.A.; Taha, A.S.; Salem, M.Z.M.; Fares, Y.G.D.; Böhm, M.; Mohamed, M.F.; Nasser, R.A.; Pommer, V. The Effects of Iron Rust on the Ageing of Woods and Their Derived Pulp Paper. Polymers 2021, 13, 3483. https://doi.org/10.3390/polym13203483
Abo Elgat WAA, Taha AS, Salem MZM, Fares YGD, Böhm M, Mohamed MF, Nasser RA, Pommer V. The Effects of Iron Rust on the Ageing of Woods and Their Derived Pulp Paper. Polymers. 2021; 13(20):3483. https://doi.org/10.3390/polym13203483
Chicago/Turabian StyleAbo Elgat, Wael A. A., Ayman S. Taha, Mohamed Z. M. Salem, Yahia G. D. Fares, Martin Böhm, Mourad F. Mohamed, Ramadan A. Nasser, and Vojtěch Pommer. 2021. "The Effects of Iron Rust on the Ageing of Woods and Their Derived Pulp Paper" Polymers 13, no. 20: 3483. https://doi.org/10.3390/polym13203483
APA StyleAbo Elgat, W. A. A., Taha, A. S., Salem, M. Z. M., Fares, Y. G. D., Böhm, M., Mohamed, M. F., Nasser, R. A., & Pommer, V. (2021). The Effects of Iron Rust on the Ageing of Woods and Their Derived Pulp Paper. Polymers, 13(20), 3483. https://doi.org/10.3390/polym13203483

